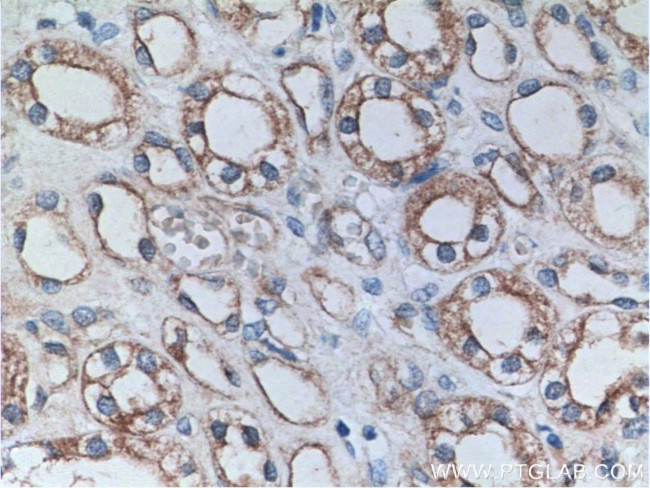
PTPRS Antibody in Immunohistochemistry (Paraffin) (IHC (P))

Search
Proteintech
PTPRS Polyclonal Antibody
{{$productOrderCtrl.translations['antibody.pdp.commerceCard.promotion.promotions']}}
{{$productOrderCtrl.translations['antibody.pdp.commerceCard.promotion.viewpromo']}}
{{$productOrderCtrl.translations['antibody.pdp.commerceCard.promotion.promocode']}}: {{promo.promoCode}} {{promo.promoTitle}} {{promo.promoDescription}}. {{$productOrderCtrl.translations['antibody.pdp.commerceCard.promotion.learnmore']}}
产品信息
13008-1-AP
种属反应
已发表种属
宿主/亚型
分类
类型
抗原
偶联物
形式
浓度
规格
纯化类型
保存液
内含物
保存条件
运输条件
产品详细信息
Immunogen sequence: GGCAAEEPP RFIKEPKDQI GVSGGVASFV CQATGDPKPR VTWNKKGKKV NSQRFETIEF DESAGAVLRI QPLRTPRDEN VYECVAQNSV GEITVHAKLT VLRGP (25-128 aa encoded by B C029496)
靶标信息
PTPRS cell surface receptor that binds to glycosaminoglycans, including chondroitin sulfate proteoglycans and heparan sulfate proteoglycan. Binding to chondroitin sulfate and heparan sulfate proteoglycans has opposite effects on PTPRS oligomerization and regulation of neurite outgrowth. Contributes to the inhibition of neurite and axonal outgrowth by chondroitin sulfate proteoglycans, also after nerve transection. Plays a role in stimulating neurite outgrowth in response to the heparan sulfate proteoglycan GPC2. Required for normal brain development, especially for normal development of the pituitary gland and the olfactory bulb. Functions as tyrosine phosphatase. Mediates dephosphorylation of NTRK1, NTRK2 and NTRK3. Plays a role in down-regulation of signaling cascades that lead to the activation of Akt and MAP kinases. Down-regulates TLR9-mediated activation of NF-kappa-B, as well as production of TNF, interferon alpha and interferon beta.
仅用于科研。不用于诊断过程。未经明确授权不得转售。
生物信息学
蛋白别名: LAR-PTP2; Leukocyte common antigen-related protein-tyrosine phosphatase 2; leukocyte common antigen-related proten-tyrosine phosphatase 2; protein tyrosine phosphatase PTPsigma; protein tyrosine phosphatase, receptor type, D; PTPNU-3; R-PTP-S; R-PTP-sigma; Receptor-type tyrosine-protein phosphatase S; Receptor-type tyrosine-protein phosphatase sigma; tissue-specific protein tyrosine phosphatase
基因别名: AL022616; Larptp2; PTP; PTP-NU3; PTP-sigma; PTPNU-3; Ptprd; PTPRS; PTPSIGMA; Ptpsigma.; Ptpt9; R-PTP-S; R-PTP-sigma; Rptpd; RPTPsigma
UniProt ID: (Human) Q13332, (Mouse) B0V2N1, (Rat) Q64605
Entrez Gene ID: (Human) 5802, (Mouse) 19280, (Rat) 25529